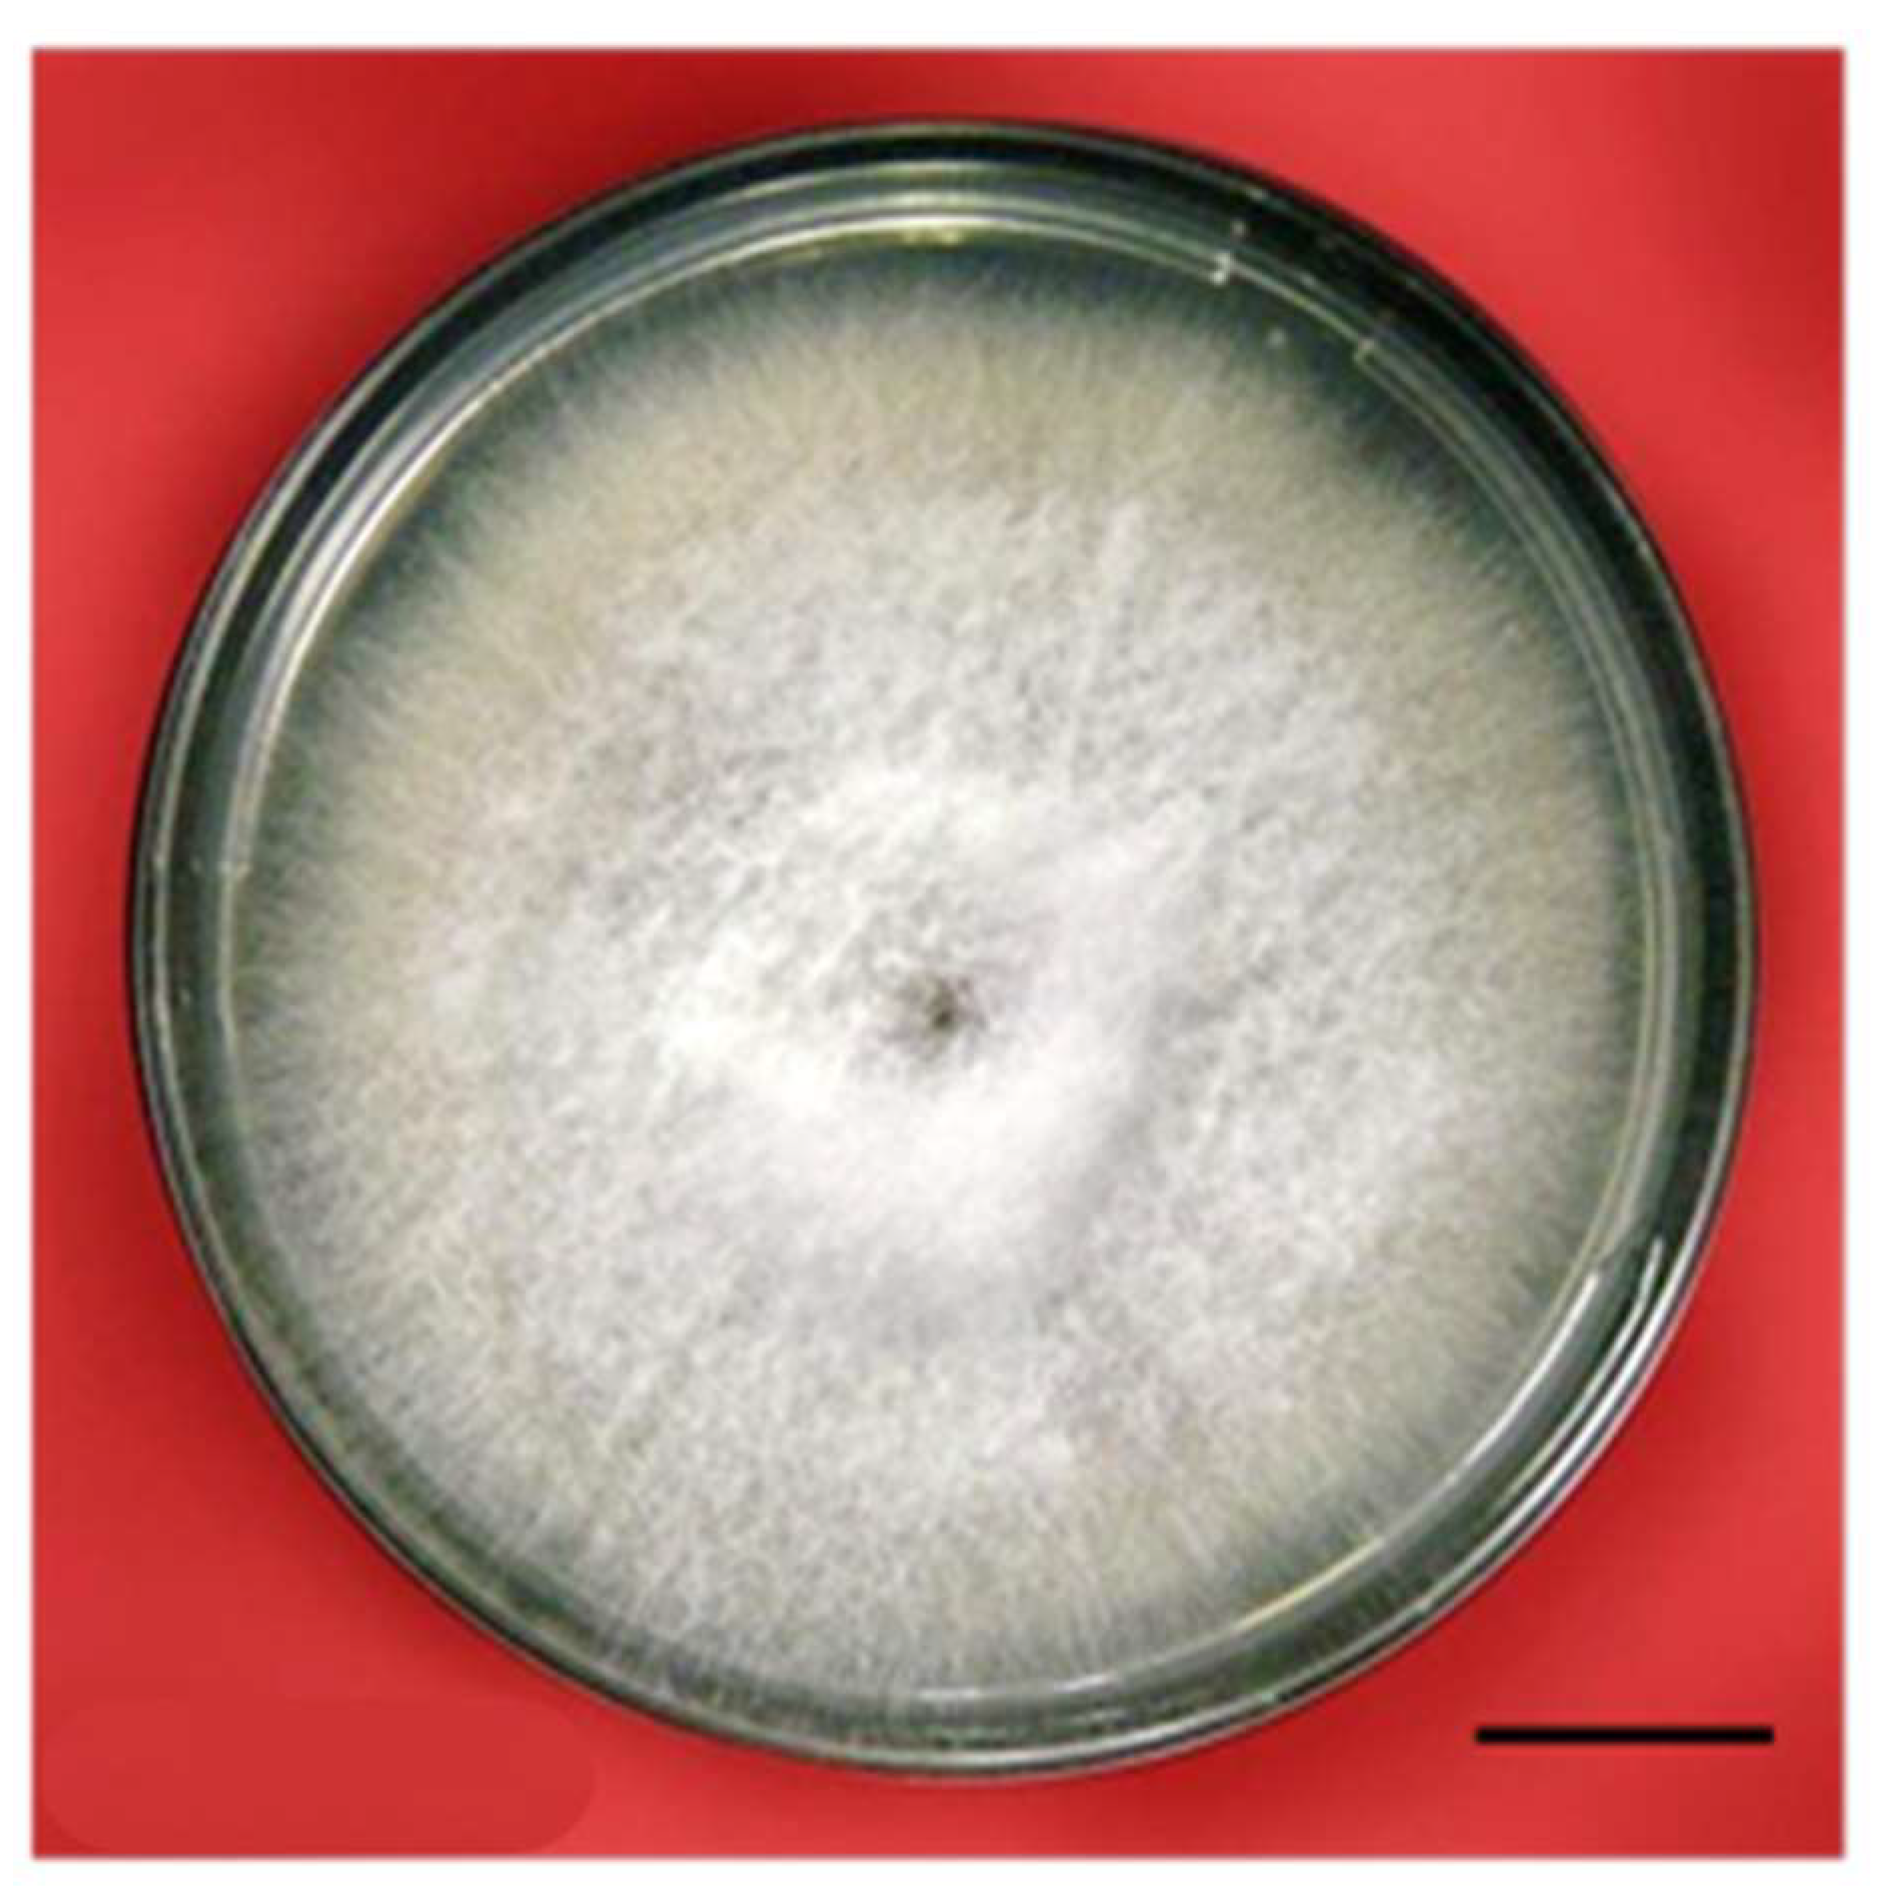
Plants 12 03373 g005

Fungal Elicitation Enhances Vincristine and Vinblastine Yield in the Embryogenic Tissues of Catharanthus roseus
Abstract
:1. Introduction
2. Results
2.1. Callus Induction and Biomass Growth in a Medium Containing a Fusarium oxysporum Extract
2.2. F. oxysporum Treatments and the Number of Embryos
2.3. The Maturation and Germination of Somatic Embryos in a Medium Containing F. oxysporum
2.4. Vinblastine and Vincristine Yields
2.5. Fusarium Oxysporum Elicitation and Biochemical Attributes
2.5.1. Sugar, Proline, and Protein Contents
2.5.2. SOD, CAT, and APX Activities
3. Discussion
4. Materials and Methods
4.1. In Vitro Seed Germination and Culture Conditions
4.2. The Procurement and Culture of Fungi and the Preparation of the Elicitor
4.3. Callus Induction under Fungus-Treated and Non-Treated Conditions
4.4. The Proliferation, Maturation, and Germination of Embryos under the Influence of Biotic Elicitors
4.5. Vinblastine and Vincristine Quantification through HPTLC
4.6. Estimation of Total Sugar, Proline, and Protein Contents
4.7. Assay of Antioxidant Enzyme Activity
4.8. Statistical Analysis
5. Conclusions
Author Contributions
Funding
Data Availability Statement
Acknowledgments
Conflicts of Interest
References
- Almagro, L.; Fernández-Pérez, F.; Pedreño, M.A. Indole alkaloids from Catharanthus roseus: Bioproduction and their effect on human health. Molecules 2015, 20, 2973–3000. [Google Scholar] [CrossRef] [PubMed]
- Mujib, A.; Ilah, A.; Aslam, J.; Fatima, S.; Siddiqui, Z.H. Catharanthus roseus alkaloids: Application of biotechnology for improving yield. Plant Growth Regul. 2012, 68, 111–127. [Google Scholar] [CrossRef]
- Hemmati, N.; Azizi, M.; Spina, R.; Dupire, F.; Arouei, H.; Saeedi, M.; Laurain-Mattar, D. Accumulation of ajmalicine and vinblastine in cell cultures is enhanced by endophytic fungi of Catharanthus roseus cv. Icy Pink. Ind. Crops Prod. 2020, 158, 112776. [Google Scholar] [CrossRef]
- Birat, K.; Binsuwaidan, R.; Siddiqi, T.O.; Mir, S.R.; Alshammari, N.; Adnan, M.; Nazir, R.; Ejaz, B.; Malik, M.Q.; Dewangan, R.P.; et al. Report on vincristine producing endophytic fungus Nigrospora zimmermanii from leaves of Catharanthus roseus. Metabolites 2022, 12, 1119. [Google Scholar] [CrossRef]
- Singh, N.R.; Rath, S.K.; Behera, S.; Naik, S.K. In vitro secondary metabolite production through fungal elicitation: An approach for sustainability. In Fungal Nanobionics: Principles and Applications; Springer: Singapore, 2018; pp. 215–242. [Google Scholar]
- Satheesan, J.; Sabu, K.K. Endophytic fungi for a sustainable production of major plant bioactive compounds. In Plant-Derived Bioactives: Production, Properties and Therapeutic Applications; Springer: Berlin/Heidelberg, Germany, 2020; pp. 195–207. [Google Scholar]
- Mujib, A.; Tonk, D.; Gulzar, B.; Maqsood, M.; Ali, M. Quantification of taxol by high performance thin layer chromatography (HPTLC) in Taxus wallichiana callus cultivated in vitro. BioTechnologia 2020, 101, 337–347. [Google Scholar] [CrossRef]
- Naik, P.M.; Al-Khayri, J.M. Impact of abiotic elicitors on in vitro production of plant secondary metabolites: A review. J. Adv. Res. Biotechnol. 2016, 1, 1–7. [Google Scholar]
- Coste, A.; Vlase, L.; Halmagyi, A.; Deliu, C.; Coldea, G. Effects of plant growth regulators and elicitors on production of secondary metabolites in shoot cultures of Hypericum hirsutum and Hypericum maculatum. Plant Cell Tissue Organ Cult. PCTOC 2011, 106, 279–288. [Google Scholar] [CrossRef]
- Halder, M.; Sarkar, S.; Jha, S. Elicitation: A biotechnological tool for enhanced production of secondary metabolites in hairy root cultures. Eng. Life Sci. 2019, 19, 880–895. [Google Scholar] [CrossRef]
- Siddiqui, Z.H.; Mujib, A. Accumulation of vincristine in calcium chloride elicitated Catharanthus roseus cultures. Nat. Prod. J. 2012, 2, 307–315. [Google Scholar] [CrossRef]
- Syeed, R.; Mujib, A.; Dewir, Y.H.; Malik, M.Q.; Bansal, Y.; Ejaz, B.; Alsughayyir, A. Methyl Jasmonate elicitation for in vitro lycorine accumulation in three Zephyranthes species and comparative analysis of tissue-cultured and field grown plants. Horticulturae 2023, 9, 832. [Google Scholar] [CrossRef]
- Birat, K.; Siddiqi, T.O.; Mir, S.R.; Aslan, J.; Bansal, R.; Khan, W.; Dewangan, R.P.; Panda, B.P. Enhancement of vincristine under in vitro culture of Catharanthus roseus supplemented with Alternaria sesami endophytic fungal extract as a biotic elicitor. Int. Microbiol. 2022, 25, 275–284. [Google Scholar] [CrossRef] [PubMed]
- Singh, S.; Pandey, S.S.; Shanker, K.; Kalra, A. Endophytes enhance the production of root alkaloids ajmalicine and serpentine by modulating the terpenoid indole alkaloid pathway in Catharanthus roseus roots. J. Appl. Microbiol. 2020, 128, 1128–1142. [Google Scholar] [CrossRef] [PubMed]
- Alcalde, M.A.; Perez-Matas, E.; Escrich, A.; Cusido, R.M.; Palazon, J.; Bonfill, M. Biotic elicitors in adve in adventitious and hairy root cultures: A review from 2010 to 2022. Molecules 2022, 27, 5253. [Google Scholar] [CrossRef] [PubMed]
- Wilczańska-Barska, A.; Królicka, A.; Głód, D.; Majdan, M.; Kawiak, A.; Krauze-Baranowska, M. Enhanced accumulation of secondary metabolites in hairy root cultures of Scutellaria lateriflora following elicitation. Biotechnol. Lett. 2012, 34, 1757–1763. [Google Scholar] [CrossRef]
- Hedayati, A.; Hemmaty, S.; Nourozi, E.; Amirsadeghi, A. Effect of yeast extract on H6H gene expression and tropane alkaloids production in Atropa belladonna L. hairy roots. Russ. J. Plant Physiol. 2021, 68, 102–109. [Google Scholar] [CrossRef]
- Pandey, S.S.; Singh, S.; Babu, C.V.; Shanker, K.; Srivastava, N.K.; Shukla, A.K.; Kalra, A. Fungal endophytes of Catharanthus roseus enhance vindoline content by modulating structural and regulatory genes related to terpenoid indole alkaloid biosynthesis. Sci. Rep. 2016, 6, 26583. [Google Scholar] [CrossRef]
- Taleb, A.M.A.; Ramadan, E.H.; Zaki, S.A.; Salama, A.B.; Kapiel, T.Y. Impact of fungal elicitor and culture conditions on induction of calli and alkaloids production in Narcissus tazetta var. italicus tissue cultures. Plant Cell. Biotechnol. Mol. Biol. 2021, 22, 88–98. [Google Scholar]
- Bhambhani, S.; Karwasara, V.S.; Dixit, V.K.; Banerjee, S. Enhanced production of vasicine in Adhatoda vasica (L.) Nees. cell culture by elicitation. Acta Physiol. Plant 2012, 34, 1571–1578. [Google Scholar] [CrossRef]
- Kumar, S.; Arora, N.; Upadhyay, H. Arbuscular mycorrhizal fungi: Source of secondary metabolite production in medicinal plants. In New and Future Developments in Microbial Biotechnology and Bioengineering; Singh, J., Gehlot, P., Eds.; Elsevier: Amsterdam, The Netherlands, 2021; pp. 155–164. [Google Scholar]
- Prasad, A.; Mathur, A.; Kalra, A.; Gupta, M.M.; Lal, R.K.; Mathur, A.K. Fungal elicitor- mediated enhancement in growth and asiaticoside content of Centella asiatica L. shoot cultures. Plant Growth Regul. 2013, 69, 265–273. [Google Scholar] [CrossRef]
- Ganie, I.B.; Ahmad, Z.; Shahzad, A.; Zaushintsena, A.; Neverova, O.; Ivanova, S.; Wasi, A.; Tahseen, S. Biotechnological intervention and secondary metabolite production in Centella asiatica L. Plants 2022, 30, 2928. [Google Scholar] [CrossRef]
- Espinosa-Leal, C.A.; Mora-Vásquez, S.; Puente-Garza, C.A.; Alvarez-Sosa, D.S.; García-Lara, S. Recent advances on the use of abiotic stress (water, UV radiation, atmospheric gases, and temperature stress) for the enhanced production of secondary metabolites on in vitro plant tissue culture. Plant Growth Regul. 2022, 97, 1–20. [Google Scholar] [CrossRef]
- Das, A.; Sarkar, S.; Bhattacharyya, S.; Gantait, S. Biotechnological advancements in Catharanthus roseus (L.) G. Don. Appl. Microbiol. Biotechnol. 2020, 104, 4811–4835. [Google Scholar] [CrossRef]
- Siddiqui, Z.H.; Mujib, A.; Abbas, Z.K.; Noorani, M.S.; Khan, S. Vinblastine synthesis under the influence of CaCl2 elicitation in embryogenic cell suspension culture of Catharanthus roseus. S. Afr. J. Bot. 2023, 154, 319–329. [Google Scholar] [CrossRef]
- Cai, Z.; Kastell, A.; Mewis, I.; Knorr, D.; Smetanska, I. Polysaccharide elicitors enhance anthocyanin and phenolic acid accumulation in cell suspension cultures of Vitis vinifera. Plant Cell Tissue Org. Cult. 2012, 108, 401–409. [Google Scholar] [CrossRef]
- Ben Romdhane, A.; Chtourou, Y.; Sebii, H.; Baklouti, E.; Nasri, A.; Drira, R.; Maalej, M.; Drira, N.; Rival, A.; Fki, L. Methyl jasmonate induces oxidative/nitrosative stress and the accumulation of antioxidant metabolites in Phoenix dactylifera L. Biotechnol. Lett. 2022, 44, 1323–1336. [Google Scholar] [CrossRef] [PubMed]
- Fatima, S.; Mujib, A.; Tonk, D. NaCl amendment improves vinblastine and vincristine synthesis in Catharanthus roseus: A case of stress signalling as evidenced by antioxidant enzymes activities. Plant Cell Tiss. Organ. Cult. 2015, 121, 445–458. [Google Scholar] [CrossRef]
- Mujib, A. Somatic Embryogenesis in Ornamentals and Its Applications; Springer: Berlin/Heidelberg, Germany, 2016; p. 267. [Google Scholar]
- Gulzar, B.; Mujib, A.; Malik, M.Q.; Mamgain, J.; Syeed, R.; Zafar, N. Plant tissue culture: Agriculture and industrial applications. In Transgenic Technology Based Value Addition in Plant Biotechnology; Academic Press: Cambridge, MA, USA, 2020; pp. 25–49. [Google Scholar]
- Cordeiro, D.; Pérez-Pérez, Y.; Canhoto, J.; Testillano, P.S.; Correia, S. H3K9 methylation patterns during somatic embryogenic competence expression in tamarillo (Solanum betaceum Cav.). Sci. Hortic. 2023, 321, 112259. [Google Scholar] [CrossRef]
- Robinson, J.R.; Isikhuemhen, O.S.; Anike, F.N. Fungal-Metal Interactions: A review of toxicity and homeostasis. J. Fungi 2021, 7, 225. [Google Scholar] [CrossRef]
- Karami, O.; Saidi, A. The molecular basis for stress-induced acquisition of somatic embryogenesis. Mol. Biol. Rep. 2010, 37, 2493–2507. [Google Scholar] [CrossRef]
- Feher, A. Somatic embryogenesis—Stress-induced remodeling of plant cell fate. Biochim. Biophys. Acta 2015, 1849, 385–402. [Google Scholar] [CrossRef]
- Hazubska-Przybył, T.; Ratajczak, E.; Obarska, A.; Pers-Kamczyc, E. Different roles of auxins in somatic embryogenesis efficiency in two Picea species. Int. J. Mol. Sci. 2020, 21, 3394. [Google Scholar] [CrossRef] [PubMed]
- Sosnowski, J.; Truba, M.; Vasileva, V. The impact of auxin and cytokinin on the growth and development of selected crops. Agriculture 2023, 13, 724. [Google Scholar] [CrossRef]
- Isah, T.; Umar, S.; Mujib, A.; Sharma, M.P.; Rajasekharan, P.E.; Zafar, N.; Frukh, A. Secondary metabolism of pharmaceuticals in the plant in vitro cultures: Strategies, approaches, and limitations to achieving higher yield. Plant Cell Tissue Organ. Cult. 2018, 132, 239–265. [Google Scholar]
- Espinosa-Leal, C.A.; Puente-Garza, C.A.; García-Lara, S. In vitro plant tissue culture: Means for production of biological active compounds. Planta 2018, 248, 1–18. [Google Scholar] [CrossRef] [PubMed]
- Tonk, D.; Mujib, A.; Maqsood, M.; Ali, M.; Zafar, N. Aspergillus flavus fungus elicitation improves vincristine and vinblastine yield by augmenting callus biomass growth in Catharanthus roseus. Plant Cell Tissue Organ Cult. PCTOC 2016, 126, 291–303. [Google Scholar] [CrossRef]
- Siddiqui, Z.H.; Mujib, A.; Maqsood, M. Liquid overlaying improves somatic embryogenesis in Catharanthus roseus. Plant Cell Tiss Org Cult 2011, 104, 247–256. [Google Scholar] [CrossRef]
- Li, Y.; Kong, D.; Fu, Y.; Sussman, M.R.; Wu, H. The effect of developmental and environmental factors on secondary metabolites in medicinal plants. Plant Physiol. Biochem. 2020, 148, 80–89. [Google Scholar] [CrossRef]
- Garagounis, C.; Delkis, N.; Papadopoulou, K.K. Unraveling the roles of plant specialized metabolites: Using synthetic biology to design molecular biosensors. New Phytol. 2021, 231, 1338–1352. [Google Scholar] [CrossRef]
- Ikeuchi, M.; Sugimoto, K.; Iwase, A. Plant callus: Mechanisms of induction and repression. Plant Cell 2013, 25, 3159–3173. [Google Scholar] [CrossRef]
- Guo, F.; Wang, H.; Lian, G.; Cai, G.; Liu, W.; Zhang, H.; Li, D.; Zhou, C.; Han, N.; Zhu, M.; et al. Initiation of scutellum-derived callus is regulated by an embryo-like developmental pathway in rice. Commun. Biol. 2023, 6, 457. [Google Scholar] [CrossRef]
- Hosseinifard, M.; Stefaniak, S.; Ghorbani Javid, M.; Soltani, E.; Wojtyla, Ł.; Garnczarska, M. Contribution of exogenous proline to abiotic stresses tolerance in plants: A Review. Int. J. Mol. Sci. 2022, 23, 5186. [Google Scholar] [CrossRef]
- Dvojković, K.; Plavšin, I.; Novoselović, D.; Šimić, G.; Lalić, A.; Čupić, T.; Horvat, D.; Viljevac Vuletić, M. Early antioxidative response to desiccant-stimulated drought stress in field-grown traditional wheat varieties. Plants 2023, 12, 249. [Google Scholar] [CrossRef]
- Lim, C.Y.; Lee, K.J.; Oh, D.B.; Ko, K. Effect of the developmental stage and tissue position on the expression and glycosylation of recombinant glycoprotein GA733-FcK in transgenic plants. Front. Plant Sci. 2015, 5, 778. [Google Scholar] [CrossRef] [PubMed]
- Li, J.; Wang, Y.; Wei, J.; Pan, Y.; Su, C.; Zhang, X. A tomato proline-, lysine-, and glutamic-rich type gene SpPKE1 positively regulates drought stress tolerance. Biochem. Biophys. Res. Comm. 2018, 499, 777–782. [Google Scholar] [CrossRef] [PubMed]
- Kononczuk, J.; Czyzewska, U.; Moczydlowska, J.; Surażyński, A.; Palka, J.; Miltyk, W. Proline oxidase (pox) as a target for cancer therapy. Curr. Drug Targets 2015, 16, 1464–1469. [Google Scholar] [CrossRef] [PubMed]
- Chalecka, M.; Kazberuk, A.; Palka, J.; Surazynski, A. P5C as an interface of proline interconvertible amino acids and its role in regulation of cell survival and apoptosis. Int. J. Mol. Sci. 2021, 22, 11763. [Google Scholar] [CrossRef]
- Cohen, S.P.; Leach, J.E. Abiotic and biotic stresses induce a core transcriptome response in rice. Sci. Rep. 2019, 9, 6273. [Google Scholar] [CrossRef]
- Alexander, A.; Singh, V.K.; Mishra, A. Overexpression of differentially expressed AhCytb6 gene during plant-microbe interaction improves tolerance to N2 deficit and salt stress in transgenic tobacco. Sci. Rep. 2021, 11, 1–20. [Google Scholar] [CrossRef]
- Gutiérrez-Beltrán, E.; Personat, J.M.; de la Torre, F.; Del Pozo, O. A universal stress protein involved in oxidative stress is a phosphorylation target for protein kinase CIPK6. Plant Physiol. 2017, 173, 836–852. [Google Scholar] [CrossRef]
- Ren, H.; Zhao, X.; Li, W.; Hussain, J.; Qi, G.; Liu, S. Calcium signaling in plant programmed cell death. Cells 2021, 10, 1089. [Google Scholar] [CrossRef]
- Leonowicz, G.; Trzebuniak, K.F.; Zimak-Piekarczyk, P.; Ślesak, I.; Mysliwa-Kurdziel, B. The activity of superoxide dismutases (SODs) at the early stages of wheat deetiolation. PLoS ONE 2018, 13, e0194678. [Google Scholar] [CrossRef] [PubMed]
- Zafar, N.; Mujib, A.; Ali, M.; Tonk, D.; Gulzar, B. Aluminum chloride elicitation (amendment) improves callus biomass growth and reserpine yield in Rauvolfia serpentina leaf callus. Plant Cell Tiss. Organ. Cult. 2017, 130, 357–368. [Google Scholar] [CrossRef]
- Sofo, A.; Scopa, A.; Nuzzaci, M.; Vitti, A. Ascorbate peroxidase and catalase activities and their genetic regulation in plants subjected to drought and salinity stresses. Int. J. Mol. Sci. 2015, 16, 13561–13578. [Google Scholar] [CrossRef] [PubMed]
- Gutiérrez-Martínez, P.B.; Torres-Morán, M.I.; Romero-Puertas, M.C.; Casas-Solís, J.; Zarazúa-Villaseñor, P.; Sandoval-Pinto, E.; Ramírez-Hernández, B.C. Assessment of antioxidant enzymes in leaves and roots of Phaseolus vulgaris plants under cadmium stress. Biotecnia Hermosillo 2020, 22, 110–118. [Google Scholar] [CrossRef]
- Rolly, N.K.; Imran, Q.M.; Lee, I.-J.; Yun, B.-W. Salinity stress-mediated suppression of expression of salt overly sensitive signaling pathway genes suggests negative regulation by AtbZIP62 transcription factor in Arabidopsis thaliana. Int. J. Mol. Sci. 2020, 21, 1726. [Google Scholar] [CrossRef] [PubMed]
- Scholtmeijer, K.; van den Broek, L.A.M.; Fischer, A.R.H.; van Peer, A. Potential protein production from lignocellulosic materials using edible mushroom forming fungi. J. Agric. Food Chem 2023, 71, 4450–4457. [Google Scholar] [CrossRef]
- Barbosa, L.P.; Kemmelmeier, C. Chemical composition of the hyphal wall from Fusarium graminearum. Exp. Mycol. 1993, 17, 274–283. [Google Scholar] [CrossRef]
- Garcia-Rubio, R.; de Oliveira, H.C.; Rivera, J.; Trevijano-Contador, N. The Fungal Cell Wall: Candida, Cryptococcus, and Aspergillus Species. Front. Microbiol. 2020, 10, 2993. [Google Scholar] [CrossRef]
- Junaid, A.; Mujib, A.; Bhat, M.A.; Sharma, M.P. Somatic embryo proliferation, maturation and germination in Catharanthus roseus. Plant Cell Tissue Org. Cult. 2006, 84, 325–332. [Google Scholar] [CrossRef]
- Thakur, M.; Bhattacharya, S.; Khosla, P.K.; Puri, S. Improving production of plant secondary metabolites through biotic and abiotic elicitation. J. Appl. Res. Med. Aromat. Plants 2019, 12, 1–12. [Google Scholar] [CrossRef]
- Ramirez-Estrada, K.; Vidal-Limon, H.; Hidalgo, D.; Moyano, E.; Golenioswki, M.; Cusidó, R.M.; Palazon, J. Elicitation, an effective strategy for the biotechnological production of bioactive high-added value compounds in plant cell factories. Molecules 2016, 21, 182. [Google Scholar] [CrossRef] [PubMed]
- Jeyasri, R.; Muthuramalingam, P.; Karthick, K.; Shin, H.; Choi, S.H.; Ramesh, M. Methyl jasmonate and salicylic acid as powerful elicitors for enhancing the production of secondary metabolites in medicinal plants: An updated review. Plant Cell Tiss. Organ. Cult. 2023, 153, 447–458. [Google Scholar] [CrossRef]
- Abdul Malik, N.A.; Kumar, I.S.; Nadarajah, K. Elicitor and receptor molecules: Orchestrators of plant defense and immunity. Int. J. Mol. Sci. 2020, 21, 963. [Google Scholar] [CrossRef]
- Guo, J.; Cheng, Y. Advances in fungal elicitor-triggered plant immunity. Int. J. Mol. Sci. 2022, 23, 12003. [Google Scholar] [CrossRef] [PubMed]
- Staniszewska, I.; Krolicka, A.; Malinski, E.; Jojkowska, E.; Szafranek, J.Z. Elicitation of secondary metabolites is in vitro cultures of Ammi majus L. Enzym. Microb. Technol. 2003, 33, 565–568. [Google Scholar] [CrossRef]
- Miura, Y.; Hirata, K.; Miyamoto, K.; Uchida, K. Formation of vinblastine from multiple shoot culture of Catharanthus roseus. Planta Med. 1988, 54, 8–20. [Google Scholar] [CrossRef] [PubMed]
- Junaid, A.; Mujib, A.; Fatima, Z.; Sharma, M.P. Variations in vinblastine production at different stages of somatic embryogenesis, embryo, and field-grown plantlets of Catharanthus roseus L. (G) Don, as revealed by HPLC. In Vitro Cell. Dev. Biol.-Plant 2010, 46, 348–353. [Google Scholar] [CrossRef]
- Dey, P.M. Methods in Plant Biochemistry. Carbohydarates, Volume 2; Academic Press: London, UK, 1990. [Google Scholar]
- Bates, L.; Waldren, P.P.; Teare, J.D. Rapid determination of free proline of water stress studies. Plant Soil. 1973, 39, 205–207. [Google Scholar] [CrossRef]
- Bradford, M.M. A rapid and sensitive method for quantification of microgram quantities of protein, utilizing the principle of protein dye binding. Anal. Biochem. 1976, 72, 248–541. [Google Scholar] [CrossRef]
- Aebi, H. Catalase in vitro. Methods Enzymol. 1984, 105, 121–126. [Google Scholar]
- Dhindsa, R.H.; Plumb-Dhindsa, R.; Thorpe, T.A. Leaf senescence correlated with increased level of membrane permeability, lipid peroxidation and decreased level of SOD and CAT. J. Exp. Bot. 1981, 32, 93–101. [Google Scholar] [CrossRef]
- Nakano, Y.; Asada, K. Hydrogen peroxide is scavenged by ascorbate specific peroxidase in spinach chloroplasts. Plant Cell Physiol. 1981, 22, 867–880. [Google Scholar]

| Treatment | Number of Somatic Embryos/Culture |
|---|---|
| T0 | 82.53 ± 1.074 d |
| T1 | 94.36 ± 0.899 b |
| T2 | 102.69 ± 0.835 a |
| T3 | 84.78 ± 0.868 c |
| T4 | 85.14 ± 0.945 c |
| Treatment | Germination (%) | Shoot Length (mm) | Root Length (mm) |
|---|---|---|---|
| T0 | 38.56 ±1.87 c | 3.36 ± 0.30 c | 4.34 ± 0.29 b |
| T1 | 47.58 ±2.60 b | 8.96 ± 0.39 b | 4.90 ± 0.23 b |
| T2 | 56.63 ±1.88 a | 11.16 ± 0.29 a | 6.67 ± 0.30 a |
| T3 | 16.76 ±1.92 d | 1.94 ± 0.22 d | 2.12 ± 0.28 c |
| T4 | 12.7 ±1.91 e | 1.24 ± 0.21 d | 2.07 ± 0.31 c |
| Treatment | Induction | Proliferation | Maturation | Germination |
|---|---|---|---|---|
| T0 | 0.422 ± 0.010 c | 0.401 ± 0.001 b | 0.788 ± 0.005 c | 0.835 ± 0.012 c |
| T1 | 0.429 ± 0.011 b | 0.406 ± 0.0006 b | 0.813 ± 0.0007 b | 0.861 ± 0.009 b |
| T2 | 0.451 ± 0.007 a | 0.417 ± 0.0009 a | 0.839 ± 0.002 a | 0.886 ± 0.011 a |
| T3 | 0.408 ± 0.013 d | 0.395 ± 0.001 c | 0.775 ± 0.004 d | 0.827 ± 0.010 d |
| T4 | 0.415 ± 0.011 d | 0.392 ± 0.003 c | 0.771 ± 0.001 d | 0.823 ± 0.018 d |
| Treatment | Induction | Proliferation | Maturation | Germination |
|---|---|---|---|---|
| T0 | 0.083 ± 0.014 c | 0.185 ± 0.011 c | 0.181 ± 0.002 b | 0.254 ± 0.007 c |
| T1 | 0.088 ± 0.011 b | 0.191 ± 0.008 b | 0.184 ± 0.001 b | 0.275 ± 0.011 b |
| T2 | 0.095 ± 0.010 a | 0.199 ± 0.012 a | 0.192 ± 0.0007 a | 0.307 ± 0.016 a |
| T3 | 0.076 ± 0.011 d | 0.182 ± 0.013 c | 0.170 ± 0.002 c | 0.242 ± 0.013 d |
| T4 | 0.074 ± 0.009 d | 0.177 ± 0.011 d | 0.168 ± 0.0006 c | 0.239 ± 0.008 d |
| Treatment | Sugar | Protein | Proline |
|---|---|---|---|
| T0 | 16.475 ± 0.009 d | 4.517 ± 0.018 d | 6.692 ± 0.010 d |
| T1 | 18.957 ± 0.011 b | 5.084 ± 0.011 b | 7.745 ± 0.011 b |
| T2 | 21.663 ± 0.010 a | 5.378 ± 0.013 a | 8.255 ± 0.009 a |
| T3 | 17.434 ± 0.009 c | 4.657 ± 0.019 c | 6.947 ± 0.010 c |
| T4 | 17.785 ± 0.006 c | 4.695 ± 0.016 c | 7.016 ± 0.008 c |
| Treatment | Sugar | Protein | Proline |
|---|---|---|---|
| T0 | 12.355 ± 0.011 d | 4.675 ± 0.019 d | 5.847 ± 0.010 d |
| T1 | 13.282 ± 0.008 b | 5.116 ± 0.017 b | 6.696 ± 0.008 b |
| T2 | 14.967 ± 0.010 a | 5.457 ± 0.011 a | 7.254 ± 0.009 a |
| T3 | 12.674 ± 0.011 c | 4.817 ± 0.014 c | 6.065 ± 0.008 c |
| T4 | 12.742 ± 0.009 c | 4.863 ± 0.018 c | 6.146 ± 0.010 c |
Disclaimer/Publisher’s Note: The statements, opinions and data contained in all publications are solely those of the individual author(s) and contributor(s) and not of MDPI and/or the editor(s). MDPI and/or the editor(s) disclaim responsibility for any injury to people or property resulting from any ideas, methods, instructions or products referred to in the content. |
© 2023 by the authors. Licensee MDPI, Basel, Switzerland. This article is an open access article distributed under the terms and conditions of the Creative Commons Attribution (CC BY) license (https://creativecommons.org/licenses/by/4.0/).
Share and Cite
Tonk, D.; Mujib, A.; Maqsood, M.; Khusrau, M.; Alsughayyir, A.; Dewir, Y.H. Fungal Elicitation Enhances Vincristine and Vinblastine Yield in the Embryogenic Tissues of Catharanthus roseus. Plants 2023, 12, 3373. https://doi.org/10.3390/plants12193373
Tonk D, Mujib A, Maqsood M, Khusrau M, Alsughayyir A, Dewir YH. Fungal Elicitation Enhances Vincristine and Vinblastine Yield in the Embryogenic Tissues of Catharanthus roseus. Plants. 2023; 12(19):3373. https://doi.org/10.3390/plants12193373
Chicago/Turabian StyleTonk, Dipti, Abdul Mujib, Mehpara Maqsood, Mir Khusrau, Ali Alsughayyir, and Yaser Hassan Dewir. 2023. "Fungal Elicitation Enhances Vincristine and Vinblastine Yield in the Embryogenic Tissues of Catharanthus roseus" Plants 12, no. 19: 3373. https://doi.org/10.3390/plants12193373
APA StyleTonk, D., Mujib, A., Maqsood, M., Khusrau, M., Alsughayyir, A., & Dewir, Y. H. (2023). Fungal Elicitation Enhances Vincristine and Vinblastine Yield in the Embryogenic Tissues of Catharanthus roseus. Plants, 12(19), 3373. https://doi.org/10.3390/plants12193373







